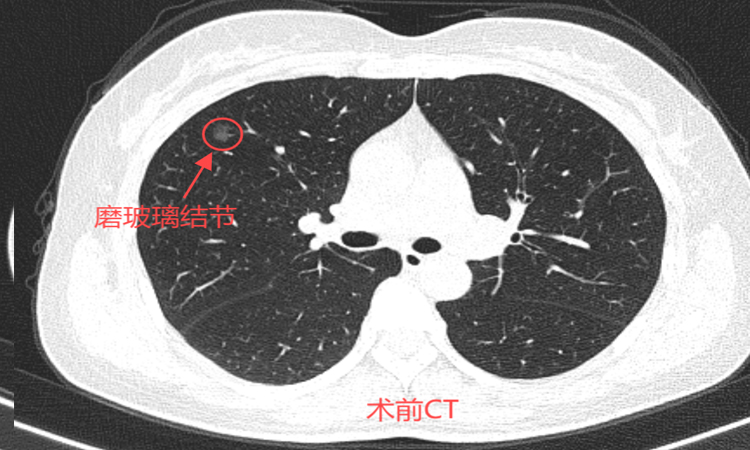

地址:长春市高新区硅谷大街3777号(硅谷大街与蔚山路交会)
电话:0431-81863396
我院首例肺多发结节微波消融
磨玻璃结节恐癌变
46岁的孙女士一年前在一次偶然的体检中发现自己双肺有多发磨玻璃结节。在医生的建议下,决定先进行随访,等结节有变化了再做处理。今年复查时发现最大结节已经达0.9*0.8cm,因担心癌变可能,于近日前往北京某三甲医院就诊,看诊后专家建议行消融治疗,经过多方咨询后就诊于我院。

患者术前肺多发磨玻璃结节
一支神针融多发病灶
根据患者病情,微创介入科刘冰主任团队联合影像科进行了术前讨论和准备,制定了治疗方案。这是一种创新的微创治疗技术,在CT引导下,将直径仅2毫米的消融针精准插入肺结节内部,利用微波产生的高温破坏病变组织,使结节的细胞变性坏死,从而达到治疗目的。


术后创口小,恢复快
在征得患者及家属同意后,刘冰主任带领团队进行了肺部多发结节微波消融术。术中,选取患者合适体位,CT确认进针通道,然后在CT引导下精准置入微波消融针至结节处进行消融。40分钟后,手术顺利完成,复查胸部CT显示:消融治疗范围覆盖目标病灶,无气胸及出血。术后患者没有特殊不适,安全返回病房。


术后刘冰主任去病房看望患者,孙女士激动不已,终于和身体里的定时炸弹告别,心里的大石头落了地,再也不用提心吊胆过日子了!出院前特制作“良言消顾虑,神针融病灶”!锦旗委托家属送给了刘冰主任。
肺结节治疗新模式
相比传统手术,微波消融术具有
这些优势
创伤小:仅需2毫米的穿刺针,无需开刀;
恢复快:患者术后72小时即可出院,极大缩短住院时间,减少治疗费用;
可重复治疗:适用于多发性结节或复发病例;
适用人群广:适合无法耐受传统手术、追求美观希望创口小或合并多种疾病的患者。
肺结节的早期发现和精准治疗是提高患者生存率和生活质量的关键。多年来,长春肿瘤医院微创介入科以“微创、安全、精准”为核心理念,不断探索、开拓创新,在肺结节消融技术方面积累了丰富经验,技术成熟、流程规范。未来,科室将进一步推动各项新技术应用和普及,为更多患者重拾健康与希望。
地址:长春市高新区硅谷大街3777号(硅谷大街与蔚山路交会)
电话:0431-81863396